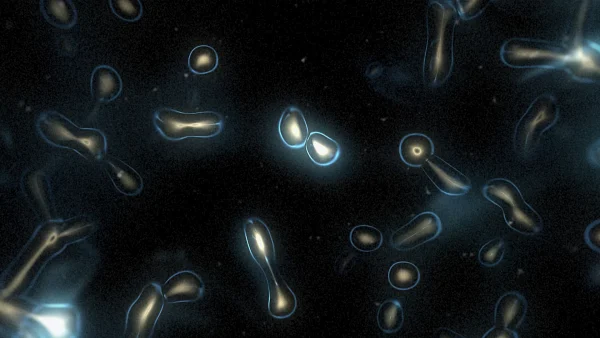

Light
Showing 21–40 of 116 resultsSorted by latest
-
Protoloop G 065
Price range: $ 4.50 through $ 7.50 -
Protoloop G 064
Price range: $ 4.50 through $ 7.50 -
Protoloop G 047
Price range: $ 4.50 through $ 7.50 -
Protoloop G 032
Price range: $ 4.50 through $ 7.50 -
Protoloop G 030
Price range: $ 4.50 through $ 7.50 -
Protoloop G 018
Price range: $ 4.50 through $ 7.50 -
Protoloop L 526
Price range: $ 4.50 through $ 7.50 -
Protoloop L 510
Price range: $ 4.50 through $ 7.50 -
Protoloop L 504
Price range: $ 4.50 through $ 7.50 -
Protoloop L 497
Price range: $ 4.50 through $ 7.50 -
Protoloop L 461
Price range: $ 4.50 through $ 7.50 -
Protoloop L 453
Price range: $ 4.50 through $ 7.50 -
Protoloop L 450
Price range: $ 4.50 through $ 7.50 -
Protoloop L 444
Price range: $ 4.50 through $ 7.50 -
Protoloop L 435
Price range: $ 4.50 through $ 7.50 -
Protoloop L 433
Price range: $ 4.50 through $ 7.50 -
Protoloop L 426
Price range: $ 4.50 through $ 7.50 -
Protoloop L 419
-
Protoloop L 410
Price range: $ 4.50 through $ 7.50 -
Protoloop L 401
Price range: $ 4.50 through $ 7.50